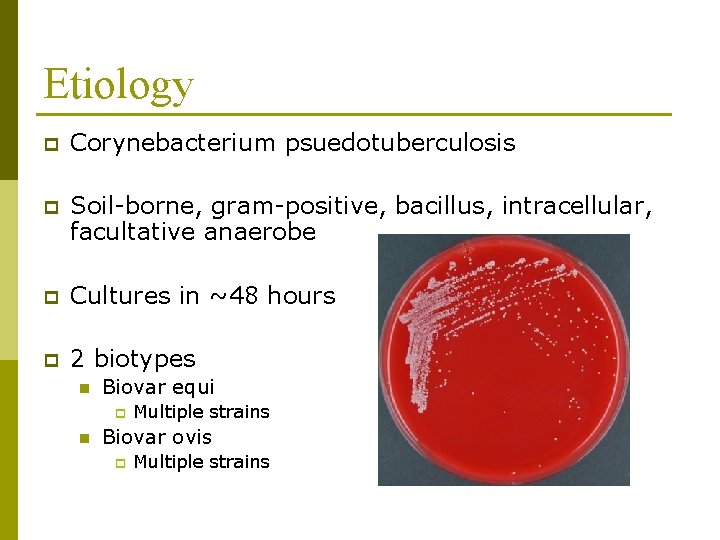
Etiology p Corynebacterium psuedotuberculosis p Soil-borne, gram-positive, bacillus, intracellular, facultative anaerobe p Cultures in

Pigeon Fever Controversial Feared Misunderstood A pain in

- Slides: 29
Pigeon Fever
Controversial
Feared
Misunderstood
A pain in the behind
Etiology p Corynebacterium psuedotuberculosis p Soil-borne, gram-positive, bacillus, intracellular, facultative anaerobe p Cultures in ~48 hours p 2 biotypes n Biovar equi p n Multiple strains Biovar ovis p Multiple strains
Epidemiology p 3 general forms n n n External abscesses 96% Internal abscesses 2% Ulcerative lymphangitis 2% p p Entry via abrasions and/or wounds to the skin or mucous membranes n p Cellulitis with multiple draining lesions Summer sores (ventral midline dermatitis) Horses, cattle, humans, sheep, goats
Epidemiology p Transmission n n p “Contagious” n n p Horse to horse contact Insects “Other” vectors Contaminated soil Not as bad as Strangles Absolute quarantine not required Survival times n n Up to 2 months in hay or shavings More than 8 months in the soil
Epidemiology p Yearly fluctuations n n Herd immunity Environmental factors Rainfall p Temperature p § Hot, dry n p Not definitively determined at this time All breeds, all ages are at risk
Risk factors p Appropriate environmental conditions n map review p <5 years or age p Horses in contact with others on summer pastures p Horses housed outside or with access to an outside paddock > stabled horses
Pathogenesis p Incubation period n 7 to 28 days p Intracellular survival p Toxins reduce disease fighting abilities n p Recovery n p Similar to that produced by the Brown Recluse spider 2 to 4 weeks Although rare, horses can develop persistent recurrent infections lasting for more than 1 year
External Abscesses p Clinical signs n n Edema - 100% of the time Lameness or stiffness 100% of the time p location, location p n n Anorexia - general malaise Fever ~25% of the time Weight loss Non-healing wounds
External Abscesses Location…
Internal Abscesses p Clinical signs n n Consistent with the involved organ or area Changes in lab work Blood p Abdominal fluid p Thoracic fluid p Urine p Serology p p Most commonly found in the liver or lungs
Internal Abscesses
Internal Abscesses
Diagnosis p Index of suspicion p Culture n Gold standard p Ultrasonography p Serology n Internal abscesses
Ultrasonography
Treatment p Time n n “You want me to. . . wait? !” Yeah… p p lets allow the abscess to “cook” for a bit Drainage n Ultrasound guidance p Determine vascularity, depth, site
Treatment p Antibiotics n Variable Penicillins, Sulfas p Rifampin, Doxycycline p p Antiinflammatories n p Bute, Banamine, Equioxx, Dexamethasone Hydrotherapy n Cold or warm
Survival Rates p <1% mortality rate associated with external abscessation with treatment p 30 to 40% mortality rate associated with internal abscessation with treatment n p 100% without Ulcerative lymphangitis n Similar mortality to internal abscesses
Long-term recovery In some horses, it can take up to 1 year for them to fully recover from the effects of pigeon fever p Some horses will never fully recover from the effects of pigeon fever p n n n They die They are chronically lame They can suffer irreversible damage to vital organs
Any questions?
Up Coming Classes September 30 th Veterinary Medicine 101: I want to be a veterinarian October 7 th Forelimb Lameness 21 st Hindlimb Lameness November 4 th Colic and GI Disease 18 th Respiratory Disease December 2 nd Disease Recognition
Thanks for your time